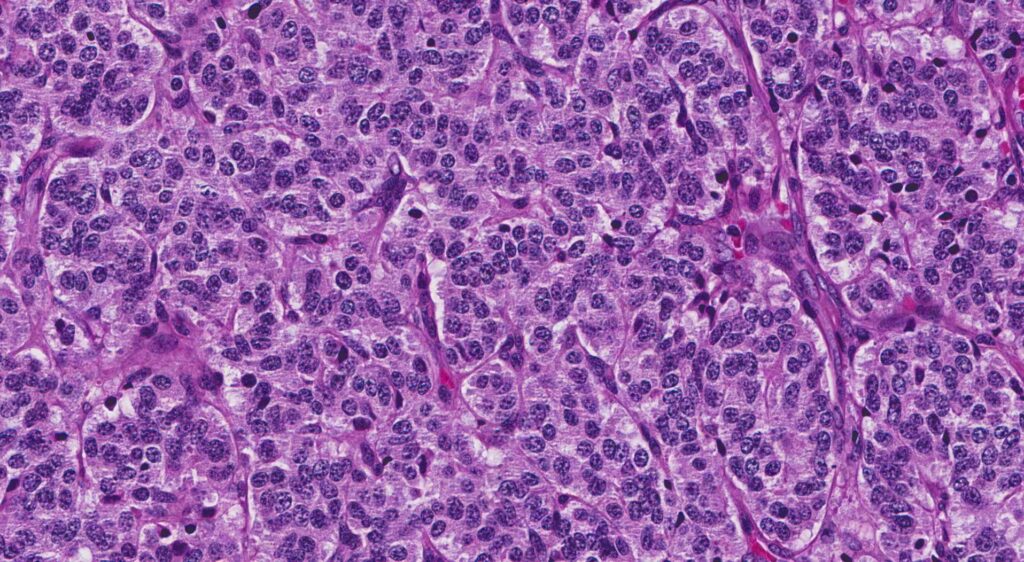
TUMORES CARCINOIDES BRONQUIALES

Los tumores carcinoides bronquiales son un tipo específico de tumor neuroendocrino que se origina en el tejido neuroendocrino del pulmón. Estos tumores, a menudo denominados carcinoides pulmonares, se clasifican generalmente como tumores neuroendocrinos malignos de bajo a grado intermedio debido a su comportamiento clínico y su perfil histopatológico.
Histológicamente, los tumores carcinoides presentan una arquitectura sólida y trabecular, con células que tienen un citoplasma escaso y núcleos redondeados. Estas células suelen mostrar una citología regular, con escaso pleomorfismo nuclear y mitosis infrecuentes. La presencia de gránulos neuroendocrinos en el citoplasma, que se evidencian mediante técnicas de tinción específicas como la inmunohistoquímica para cromogranina A y sinaptofisina, es característica de estos tumores.
Existen dos subtipos de tumores carcinoides bronquiales: el carcinoide típico y el carcinoide atípico. El carcinoide típico, que representa aproximadamente el 80% de los casos, es el de menor grado y tiene un pronóstico más favorable. Por otro lado, el carcinoide atípico, que es menos frecuente, tiene características histológicas que incluyen mayor pleomorfismo, más mitosis, y un comportamiento más agresivo que puede influir en un pronóstico menos favorable en comparación con el carcinoide típico.
Los carcinoides bronquiales suelen aparecer como lesiones pedunculadas o sésiles en los bronquios centrales, particularmente en los bronquios principales o secundarios. Estas lesiones pueden causar síntomas obstructivos como tos, hemoptisis, o síndromes de obstrucción bronquial debido al crecimiento local del tumor. A menudo, se presentan como masas solitarias en los bronquios que pueden ser visualizadas mediante técnicas de imagen como la tomografía computarizada (TC) y confirmadas a través de broncoscopía y biopsia.
En comparación con otros tumores neuroendocrinos pulmonares, como el cáncer de pulmón de células pequeñas (CPCP), los tumores carcinoides tienen un pronóstico relativamente favorable. El CPCP es un tumor neuroendocrino de alto grado, conocido por su agresividad y tendencia a diseminarse rápidamente, con una alta tasa de mortalidad asociada. Los carcinoides, en contraste, crecen más lentamente, tienen una menor tendencia a la metástasis, y suelen responder mejor a los tratamientos quirúrgicos y a la terapia dirigida.
El pronóstico de los tumores carcinoides también se ve influido por su grado de diferenciación y la presencia de características histológicas de alto grado, como las observadas en el carcinoide atípico. Los carcinoides típicos tienen una tasa de supervivencia a cinco años superior al 90%, mientras que los carcinoides atípicos y los tumores de alto grado, como el CPCP, presentan tasas significativamente más bajas.
Manifestaciones clínicas
Los síntomas comunes de los tumores carcinoides bronquiales, como hemoptisis, tos, sibilancias focales y neumonía postobstructiva recurrente, se deben a la localización y el comportamiento particular de estos tumores en el sistema respiratorio.
- Hemoptisis: La hemoptisis, o la expectoración de sangre, puede ocurrir debido a la invasión del tumor en las paredes bronquiales o por ulceración de la superficie del tumor. El crecimiento del carcinoide puede causar erosión en los vasos sanguíneos cercanos, resultando en sangrado. Esta hemorragia puede ser visible como sangre en el esputo, provocada por la fragilidad de los vasos en el área afectada.
- Tos: La tos es un síntoma común en los tumores carcinoides bronquiales debido a la obstrucción parcial o total del bronquio por el tumor. La presencia del tumor en el tracto respiratorio puede irritar la mucosa bronquial y estimular los receptores de tos. Además, el crecimiento del tumor puede inducir inflamación y secreciones, que también contribuyen a la tos persistente.
- Sibilancias Focales: Las sibilancias, que son sonidos respiratorios anormales de tono agudo, se producen cuando hay una obstrucción parcial de las vías respiratorias. Los tumores carcinoides en los bronquios centrales pueden causar una obstrucción focal, generando un flujo de aire turbulento a través de la zona estenosada y produciendo sibilancias que son auditables durante la auscultación.
- Neumonía Postobstructiva Recurrente: La obstrucción de las vías respiratorias provocada por el tumor puede llevar a la acumulación de secreciones y a la reducción del flujo de aire en las áreas pulmonares afectadas. Esta obstrucción predispone a infecciones bacterianas, resultando en neumonías recurrentes. La acumulación de secreciones y la falta de ventilación adecuada contribuyen al desarrollo de infecciones pulmonares, que pueden ser recurrentes si no se resuelve la obstrucción subyacente.
Los tumores carcinoides bronquiales localizados periféricamente son menos comunes en comparación con los carcinoides centrales. Estos tumores periféricos suelen presentarse como nódulos pulmonares solitarios que a menudo son asintomáticos, especialmente en sus etapas iniciales. La falta de síntomas específicos puede llevar a que estos tumores sean descubiertos incidentalmente en estudios de imagen realizados por otras razones.
La razón detrás de esta presentación asintomática es que los tumores periféricos no afectan directamente las vías respiratorias centrales, donde los síntomas como tos y sibilancias son más comunes. En cambio, los tumores ubicados en los segmentos pulmonares más distales pueden crecer sin provocar obstrucción significativa ni irritación de las estructuras bronquiales proximales.
El síndrome carcinoide es una manifestación rara de los tumores carcinoides y ocurre en aproximadamente el 10-20% de los pacientes con estos tumores. Se caracteriza por una triada de síntomas: enrojecimiento cutáneo, diarrea crónica y sibilancias. Estos síntomas se deben a la liberación excesiva de serotonina y otros aminas biogénicas por el tumor, lo que provoca vasodilatación (enrojecimiento), alteraciones gastrointestinales (diarrea), y constricción de las vías respiratorias (sibilancias).
El síndrome de Cushing paraneoplásico es aún menos común y se observa en una fracción muy pequeña de los pacientes con tumores carcinoides. Este síndrome es resultado de la producción ectópica de ACTH (hormona adrenocorticotrópica) por el tumor, lo que estimula la liberación de cortisol en las glándulas suprarrenales, provocando los síntomas típicos de la enfermedad de Cushing, como aumento de peso, hipertensión, y alteraciones metabólicas.
Exámenes diagnósticos
La broncoscopia de fibra óptica es una herramienta diagnóstica crucial en la evaluación de tumores carcinoides bronquiales, especialmente en las vías aéreas centrales. Durante la broncoscopia, un tubo delgado y flexible equipado con una cámara y una fuente de luz se introduce a través de la tráquea y los bronquios para visualizar directamente el interior de las vías respiratorias. En el caso de los tumores carcinoides, la broncoscopia puede revelar lesiones que presentan un aspecto característico: típicamente son de color rosa o púrpura y están ubicadas en las vías aéreas centrales. Estas lesiones tienen un estroma bien vascularizado, lo que significa que están rodeadas de una rica red de vasos sanguíneos. Esta vascularización prominente puede ser un factor contribuyente en el sangrado significativo durante la biopsia, lo cual puede complicar el procedimiento.
Los tumores carcinoides a menudo se presentan como masas pedunculadas o sésiles que se proyectan en el lumen del bronquio. Su color rosa o púrpura es indicativo de la alta vascularización, lo que es un rasgo distintivo que puede ayudar en la identificación visual durante la broncoscopia. El estroma bien vascularizado puede facilitar el crecimiento y la diseminación del tumor dentro de las vías respiratorias, y también contribuye a la posibilidad de hemorragia durante la biopsia, debido a la alta densidad de vasos sanguíneos en la lesión.
La tomografía computarizada (TC) es una técnica de imagen esencial para la localización y evaluación de la extensión de los tumores carcinoides bronquiales. La TC proporciona imágenes detalladas del pulmón y las vías respiratorias, permitiendo a los médicos identificar la localización exacta del tumor, así como su tamaño y posible invasión a estructuras circundantes. Además, la TC es útil para monitorear el crecimiento del tumor a lo largo del tiempo y para evaluar la respuesta a las intervenciones terapéuticas. En los casos de tumores periféricos, donde los síntomas pueden ser menos evidentes, la TC es particularmente valiosa para detectar nódulos pulmonares solitarios y determinar su relación con estructuras adyacentes.
La gammagrafía con octreótida es una técnica de imagen basada en la utilización de análogos de la somatostatina marcados con un isótopo radiactivo, como el indio-111 o el tecnecio-99m. Estos análogos se unen a los receptores de somatostatina que están frecuentemente expresados en las células tumorales de los tumores carcinoides. Esta técnica es especialmente útil para la localización de tumores carcinoides, ya que permite una visualización específica de las lesiones mediante la captación del marcador radiactivo por los tumores. La gammagrafía con octreótida no solo ayuda en la localización de los tumores carcinoides primarios, sino también en la detección de metástasis en otros órganos, ya que estos tumores pueden tener una tendencia a diseminarse a lo largo del tiempo.
Diagnóstico diferencial
En el diagnóstico de masas endobronquiales, es fundamental considerar diversas entidades que, aunque menos comunes que los tumores carcinoides, también pueden presentarse en las vías respiratorias. Entre estas entidades se encuentran los hamartomas, los mixomas y las lesiones amiloides, cada una con características distintivas que pueden complicar el diagnóstico diferencial.
Los hamartomas son tumores benignos que se originan a partir de un crecimiento desorganizado pero no maligno de células normales. En el pulmón, estos tumores suelen aparecer como nódulos solitarios. Su composición incluye tejido fibrocartilaginoso, adiposo y epitelial, y a menudo presentan calcificaciones que se visualizan claramente en las imágenes de tomografía computarizada (TC). En la TC, los hamartomas suelen mostrar una calcificación en «cáscara de huevo» o en patrones característicos. Aunque la broncoscopia puede revelar una masa en la vía aérea, los hamartomas suelen encontrarse más frecuentemente en el tejido pulmonar, y suelen ser asintomáticos. La biopsia o resección del nódulo confirma la presencia de estas características específicas.
Los mixomas son tumores benignos que se desarrollan a partir de tejido mesodérmico y pueden encontrarse en varias partes del cuerpo, incluido el pulmón. Cuando aparecen en las vías respiratorias, los mixomas pueden presentarse como masas solitarias que pueden obstruir el flujo de aire. Están formados por tejido mesodérmico maduro, que puede incluir componentes fibroblásticos y mucosos. En la TC, los mixomas pulmonares pueden mostrarse como nódulos bien definidos con densidades variables. La broncoscopia puede revelar estas masas, y el diagnóstico se confirma con una biopsia que muestra tejido mesodérmico sin características malignas.
El amiloide es una sustancia compuesta de proteínas fibrilares que se acumula anormalmente en los tejidos, incluyendo los pulmones. Las lesiones amiloides pulmonares pueden presentarse como masas en las vías respiratorias o infiltraciones en el tejido pulmonar. Estas lesiones pueden ser primarias, como en la amiloidosis sistémica, o secundarias a otras enfermedades como el mieloma múltiple. En la TC, las lesiones amiloides pueden aparecer como nódulos o áreas infiltrativas. Durante la broncoscopia, pueden verse depósitos en las paredes de las vías respiratorias. La biopsia revela depósitos de amiloide, confirmados por tinciones especiales como la de rojo congo, que muestran las fibras amiloides características bajo la microscopía de luz polarizada.
Estadificación
Los tumores carcinoides bronquiales se caracterizan por un crecimiento relativamente lento y su grado de agresividad está estrechamente relacionado con sus características histológicas. Estos tumores se dividen en dos categorías principales basadas en su perfil histológico y comportamiento clínico: el carcinoide típico y el carcinoide atípico.
Los tumores carcinoides típicos son considerados de bajo grado. Estos tumores tienen un crecimiento lento y una tendencia a tener un curso clínico menos agresivo. Histológicamente, el carcinoide típico se distingue por sus células uniformes con núcleos redondeados, escaso pleomorfismo y una baja tasa de mitosis. La arquitectura de estos tumores suele ser sólida o trabecular, y las células tumorales muestran una tinción positiva para marcadores neuroendocrinos como la cromogranina A y la sinaptofisina. El pronóstico para los pacientes con carcinoide típico es generalmente favorable, con una alta tasa de supervivencia a largo plazo, dado su crecimiento lento y bajo potencial de metastatización.
Por otro lado, los tumores carcinoides atípicos son considerados de grado intermedio y tienen un comportamiento clínico más agresivo en comparación con los carcinoides típicos. Histológicamente, estos tumores se caracterizan por un mayor pleomorfismo celular, una mayor tasa de mitosis y una mayor necrosis. La presencia de estas características indica una tendencia a un crecimiento más rápido y un mayor potencial para la diseminación metastásica. Aunque todavía se consideran menos agresivos en comparación con otros tumores neuroendocrinos de alto grado, como el cáncer de pulmón de células pequeñas, los carcinoides atípicos requieren un enfoque más riguroso en su manejo debido a su potencial de agresividad aumentado.
La estadificación de los tumores carcinoides bronquiales sigue el sistema TNM (Tumor, Nódulo, Metástasis) utilizado para otros tipos de cáncer de pulmón. Este sistema permite la evaluación precisa del tamaño del tumor primario (T), la afectación de los ganglios linfáticos regionales (N) y la presencia de metástasis a distancia (M). La clasificación TNM ayuda a determinar el estadio del tumor, que a su vez guía las decisiones sobre el tratamiento y el pronóstico.
Tratamiento
Para tratar los tumores carcinoides bronquiales localizados, la cirugía es el enfoque más efectivo. La intervención quirúrgica suele involucrar la extirpación completa del tumor primario, que puede requerir una lobectomía, una neumonectomía o una resección en cuña, dependiendo de la ubicación y el tamaño del tumor. Además, se realiza una disección de los ganglios linfáticos cercanos para asegurar que cualquier posible afectación en estos ganglios también sea eliminada. Esta combinación de resección del tumor y disección ganglionar es clave para manejar la enfermedad y mejorar las perspectivas de recuperación.
El pronóstico para los pacientes con tumores carcinoides bronquiales tratados quirúrgicamente es generalmente muy positivo. Los carcinoides típicos, en particular, tienen una tasa de supervivencia a cinco años que supera el 90%, gracias a su naturaleza de crecimiento lento y bajo grado de malignidad. Aunque los carcinoides atípicos presentan un pronóstico ligeramente menos favorable debido a su mayor potencial de agresividad, siguen mostrando una tasa de supervivencia bastante buena en comparación con otros tipos de cáncer pulmonar.
En cuanto a la radioterapia y la quimioterapia, estos tratamientos no suelen ser efectivos para los tumores carcinoides bronquiales. La radioterapia a menudo no logra reducir el tamaño del tumor o controlar la enfermedad, dado que estos tumores son relativamente resistentes a la radiación. De igual manera, la quimioterapia convencional tampoco resulta ser una opción eficaz, ya que los carcinoides no responden bien a los agentes quimioterapéuticos utilizados para otros tipos de cáncer pulmonar. En casos de enfermedad avanzada o recurrencia, se pueden explorar tratamientos alternativos como los análogos de somatostatina, que pueden ayudar a controlar los síntomas y el crecimiento del tumor.
Complicaciones
Los adenomas, carcinomas y otras neoplasias malignas rara vez pueden hacer metástasis en los bronquios y presentar lesiones endobronquiales.

Fuente y lecturas recomendadas:
- Girelli, L., et al. (2021). Results of surgical resection of locally advanced pulmonary neuroendocrine tumors. Annals of Thoracic Surgery, 112(2), 405. https://doi.org/10.1016/j.athoracsur.2021.05.066
- Petrella, F., et al. (2018). The role of endobronchial treatment for bronchial carcinoid: Considerations from the thoracic surgeon’s point of view. Respiration, 96(2), 204-213. https://doi.org/10.1159/000489782
- Rahouma, M., et al. (2019). Role of wedge resection in bronchial carcinoid (BC) tumors: SEER database analysis. Journal of Thoracic Disease, 11(5), 1355-1364. https://doi.org/10.21037/jtd.2019.03.12
- Singh, S., et al. (2020). Commonwealth Neuroendocrine Tumour Research Collaboration and the North American Neuroendocrine Tumor Society guidelines for the diagnosis and management of patients with lung neuroendocrine tumors: An international collaborative endorsement and update of the 2015 European Neuroendocrine Tumor Society expert consensus guidelines. Journal of Thoracic Oncology, 15(10), 1577-1589. https://doi.org/10.1016/j.jtho.2020.06.014